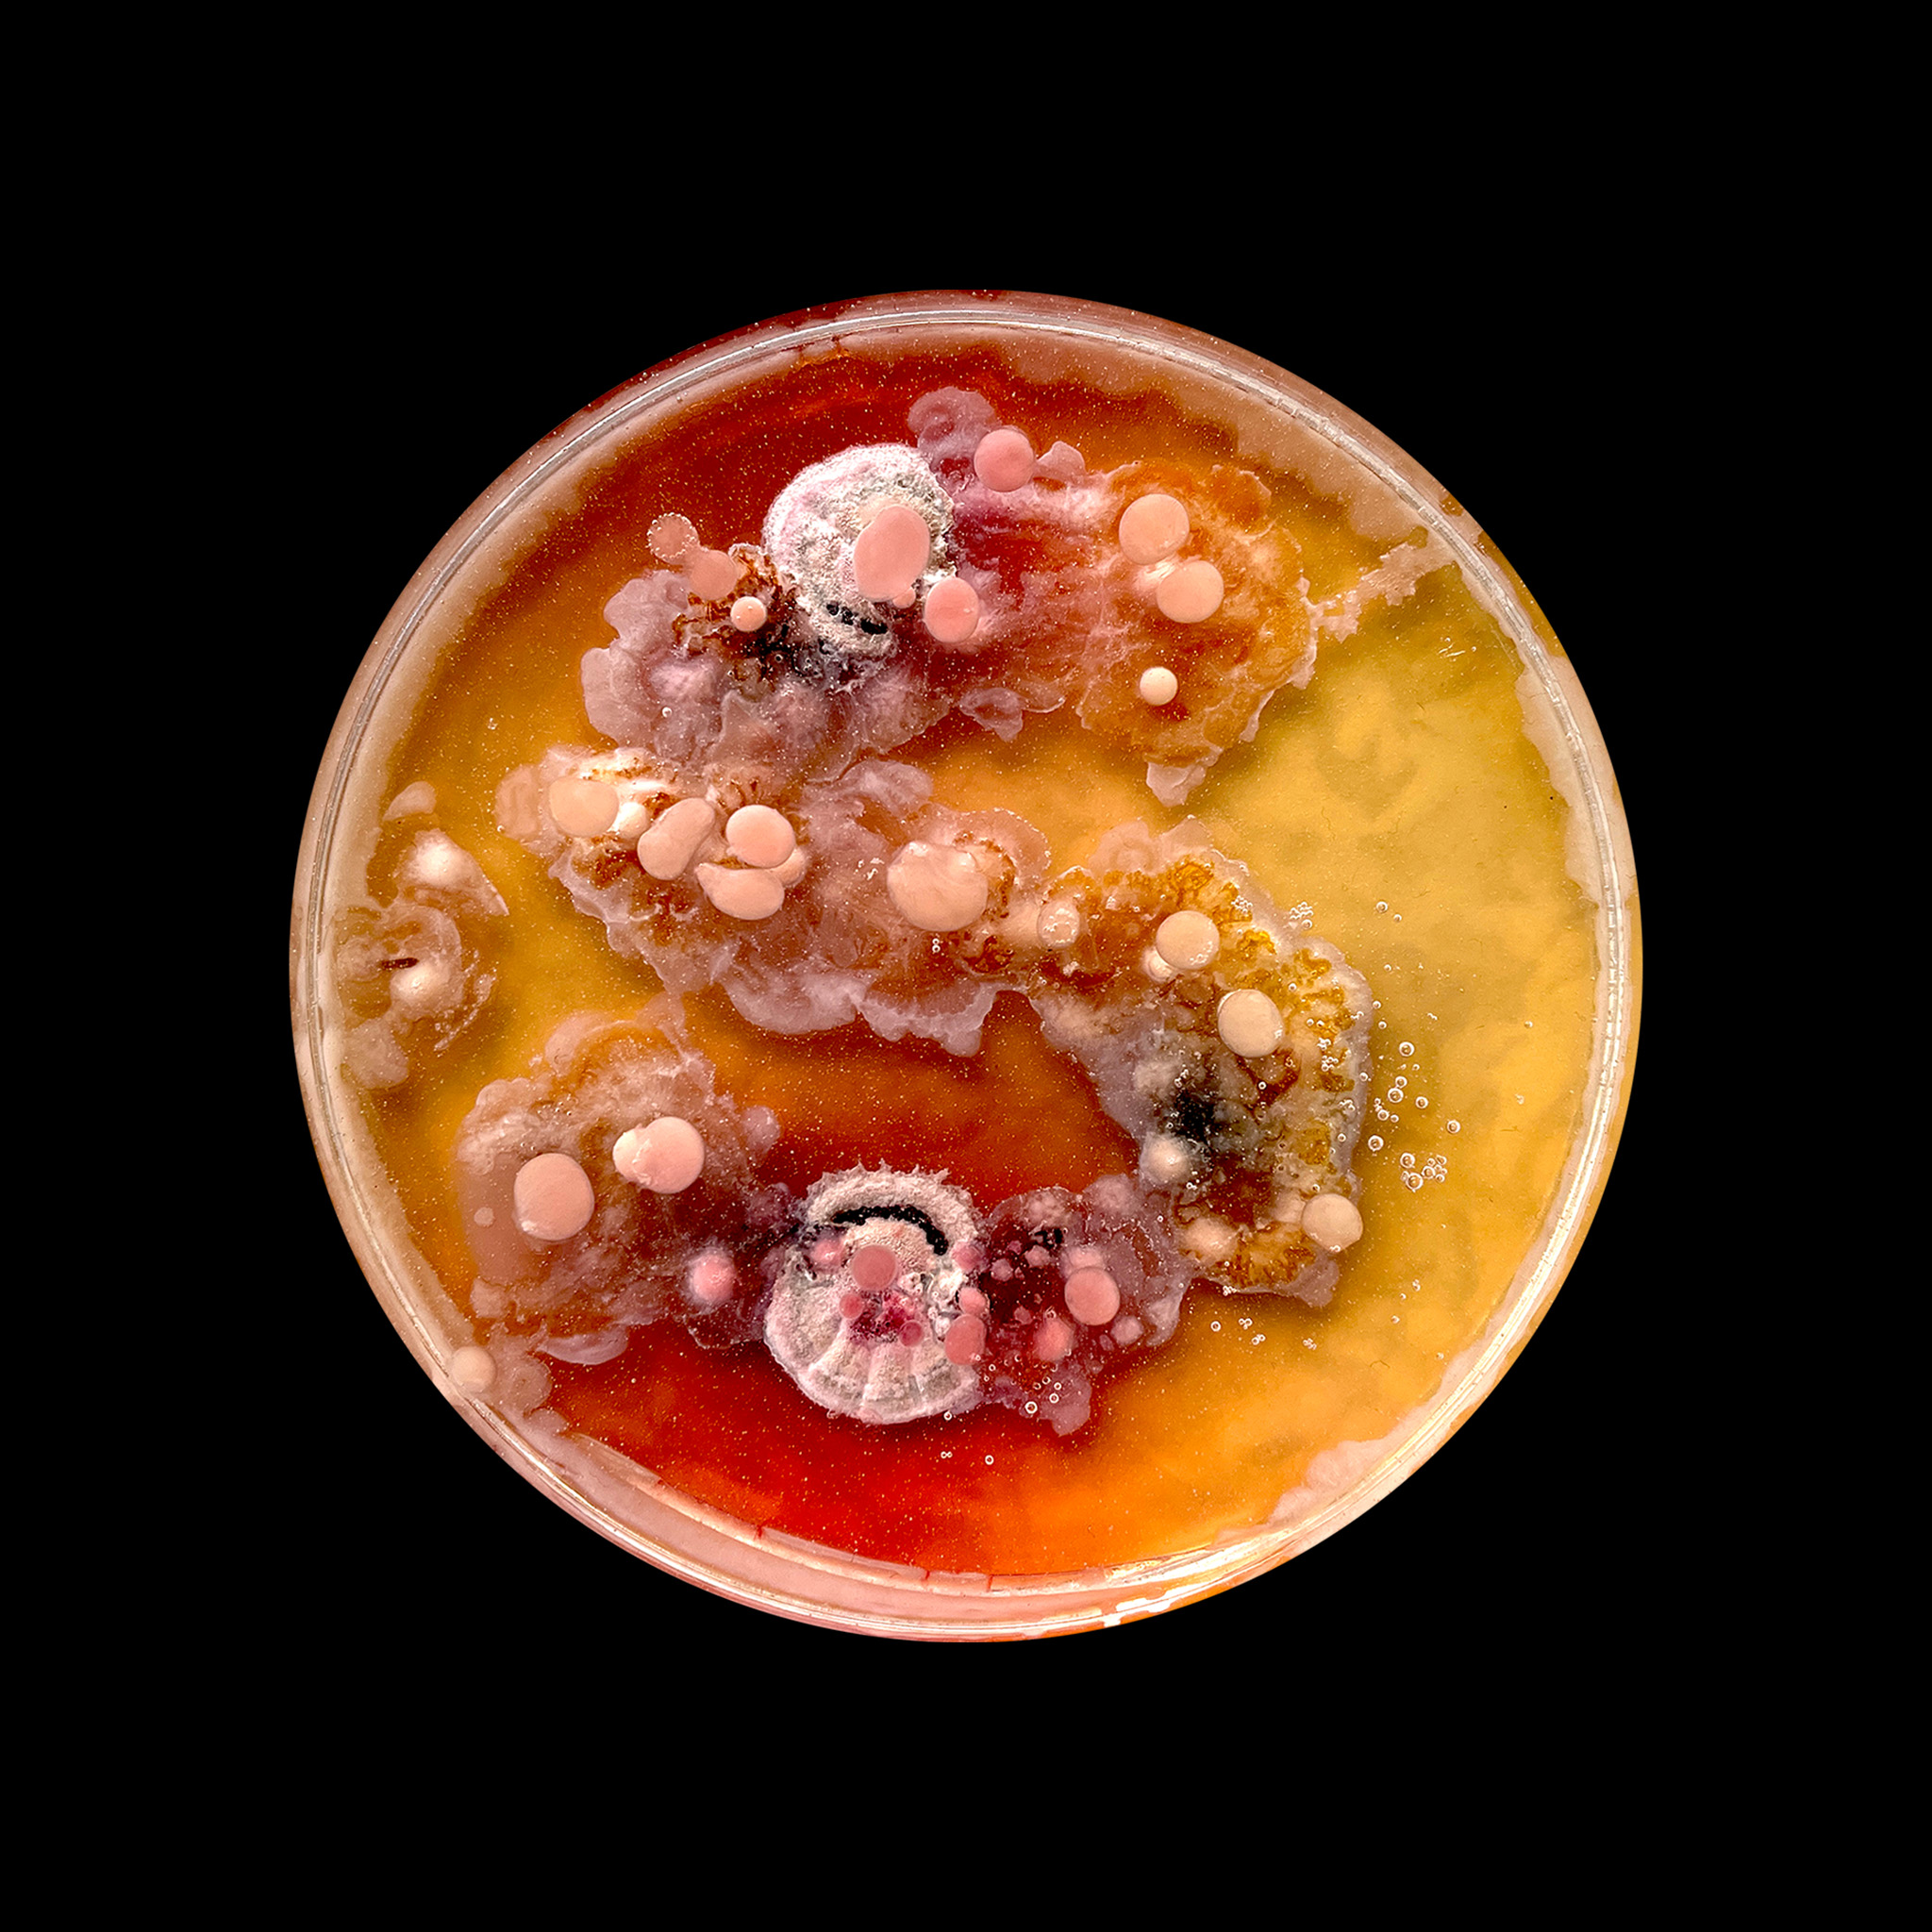
OrganicTypography-Cover

'Organic Typography' focuses on the act of typographic design as a site of interspecies collaboration. The Letterforms grown through the cultivation of microbial life within Petri dishes, drawn by the imprint of human fingers. By foregrounding other-than-human presence within the design process, it becomes less a notion of total aesthetic control and more a choreography of shared agency.